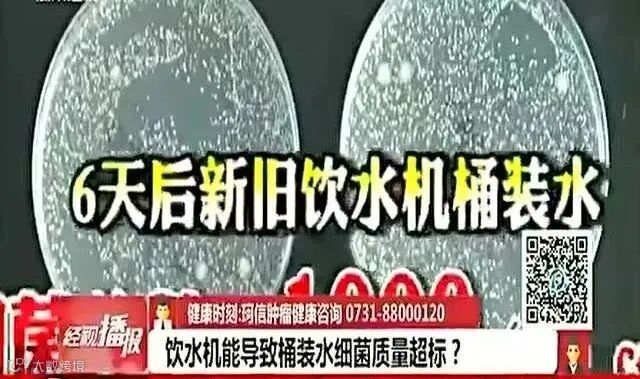

喝水,稀松平常又至关重要,虽然每天都离不开,但好像也没多大关心。

你知道吗?我们家庭中所使用的饮水机等带有储水空间的净水机,其实很脏!
水流长期静置的地方,暗藏着无数污垢,就算经常洗也难以避免。

水是生命之源,是维持生命活动所必须的物质。
人体的60%-70%由水分组成,可以促进人体新陈代谢,在调节体温、维持身体电解质平衡等方面发挥着重要作用。

传统饮水机占地空间大,且桶装水较重,家里的老人小孩以及女生,对于搬水还是比较困难的。
而普通的抽水器出水口外露,易造成饮用水撒漏,且很容易有灰尘进入,严重影响饮水健康❗️

不为搬抬沉重水桶烦恼❗️
【MAYNOS可折叠抽水器】
✅一键出水,方便省力
✅折叠设计,干净卫生
✅无线小巧,随时随地可用
✅TYPE-C接口,快速充电超方便
✅兼容性高,大小桶型皆适用



【MAYNOS可折叠抽水器】
🔺3秒安装一键出水
🔺折叠设计卫生健康
🔺随用随取方便卫生
无论是老人还是小孩都能轻松操作
出差旅行随身携带也方便
告别传统饮水机细菌滋生
让每一口水都喝得健康又安心~



🔺智能电动,一键出水
🔺强泵设计,动力十足
🔺折叠设计,干净卫生
🔺无线小巧,随时随地可用
🔺超长续航,告别频繁充电
🔺TYPE-C接口,快速充电超方便
🔺兼容性高,大小桶型皆适用



✅智能电动,一键出水
搬起大桶水真的会耗尽全身力气
尤其对于女生来说
一不小心还会造成拉伤⚠️
有了这个智能抽水器
只需连接好导管插入瓶口
轻松按键就能出水不要太方便~


✅折叠出水口
传统的抽水器出水口都暴露在外
很容易被宠物碰到❌
亦或是沾到各种灰尘❌
而MAYNOS这款折叠抽水器
折叠设计隐藏式出水口
摆脱传统抽水器出水口外露的困扰
更加卫生健康
也无需担心误触渗水


✅加长出水嘴
采用10cm加长出水嘴设计
比普通的抽水器加长3-4cm
不会出现接水接不到
或者需要侧着接的情况
无论大小杯子大小盆
都能方便接水不漏水


✅无线小巧
便携无线又小巧
做你的专属饮水管家
🔻在家中
小巧省空间,无需费力抬桶
🔻在户外
小巧便携,出行饮水更方便
随时随地都能让你喝水方便


✅强泵设计,超长续航
内置强力增压水泵
高频率出水
轻松一按瞬间装满一杯水
大容量电池超长续航
无需频繁充电
在哪都能实现轻松喝水



✅TYPE-C接口
自带TYPE-C充电口
没电了可以快速充电
电脑、充电宝、充电器都能用
充电方便随时“满血”就绪


✅大小桶型皆适用
兼容性很高的一款抽水器
无论是瓶装还是桶装水
只需手指轻轻一按
便能自动均匀出水
不挑口径多种型号皆能搭配


夏天最重要的就是大量补水
无论是办公、居家、外出
有了这个干净卫生便携的抽水器
无需担心倒水、出水问题
解决你的春夏饮水烦恼
做你的贴身饮水管家~






